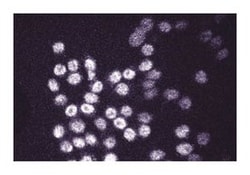
DNMT1 (DNA Methyl Transferase-1) Mouse anti-Human, Unlabeled, Clone: 18,

Learn More
DNMT1 (DNA Methyl Transferase-1) Mouse anti-Human, Unlabeled, Clone: 18, BD
Mouse Monoclonal Antibody
£237.00 - £349.11
Specifications
| Antigen | DNMT1 (DNA Methyl Transferase-1) |
|---|---|
| Clone | 18 |
| Concentration | 250μg/mL |
| Applications | Western Blot |
| Classification | Monoclonal |
Description
DNA methylation of the 5′ position of the cytosine ring within CpG dinucleotides is essential for embryonic development. This methylation may affect transcriptional repression, formation of compact chromatin structures, X chromosome inactivation, and imprinting control. Three important DNA (Cytosine-5) methyltransferases (DNMTs) include DNMT1, DNMT3A, and DNMT3B. DNMT1 contains an N-terminal regulatory domain that may target it to replication foci, and a C-terminal catalytic domain that is homologous to bacterial cystosine 5-methylases. DNMT1 knockout mice have reduced DNA methylation, defects in imprinting, and derepression of endogenous retroviruses, and are embryonic lethal. DNMT1 is responsible for DNA methylations that occur after replication, while DNMT3A and DNMT3B act to establish new methylation patterns during embryogenesis. DNMT1 and DNMT3A are expressed in most fetal tissues, while DNMT3B is expressed only in fetal liver. All of these DNMTs are found in various adult tissues and show increased expression in some tumors and cancer cell lines. Thus, DNMT methylation of CpG dinucleotides is important for regulating DNA structure during development. This antibody is routinely tested by western blot analysis. Other applications were tested at BD Biosciences Pharmingen during antibody development only or repoerted in the literature.
Immunofluorescence, Western Blotting
Specifications
| DNMT1 (DNA Methyl Transferase-1) | |
| 250μg/mL | |
| Monoclonal | |
| Mouse | |
| Cell Biology | |
| Aqueous buffered solution containing BSA, glycerol, and ≤0.09% sodium azide. | |
| IgG2b | |
| Affinity Purified | |
| DNA Methyl Transferase-1 |
| 18 | |
| Western Blot | |
| Unconjugated | |
| RUO | |
| Human | |
| Human DNMT1 aa. 476-670 | |
| Primary | |
| Store undiluted at -20°C. |
For Research Use Only.
Your input is important to us. Please complete this form to provide feedback related to the content on this product.